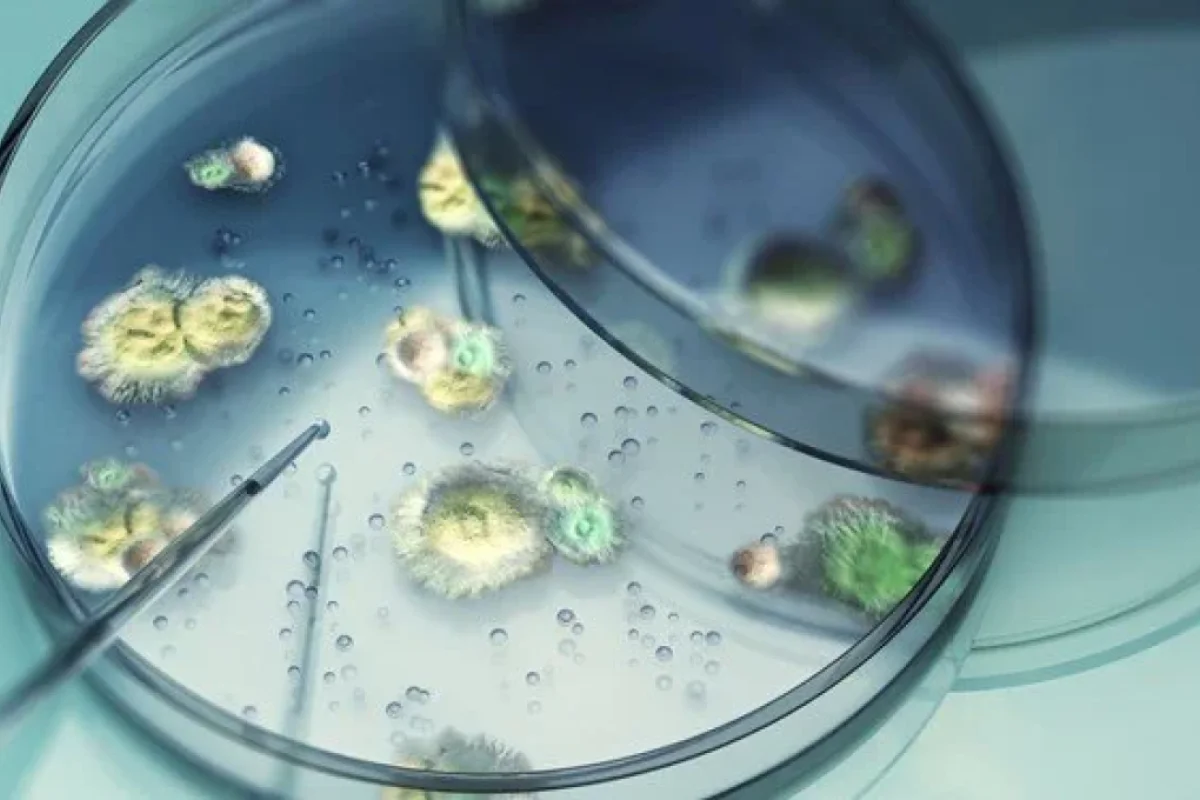
Ölümcül göbələk yayılır

Ölümcül göbələk yayılır
Sağlamlıq
Sağlamlıq
İnsan toxumasını içəridən çürüdə bilən ölümcül göbələk ABŞ-da sürətlə yayılır. Ekspertlər xəbərdarlıq edirlər ki, bu təhlükə iqlim dəyişikliyi ilə daha da böyüyə bilər.
News24.az xəbər verir ki, "Aspergillus fumigatus" adlanan göbələk havada daşına bilən mikroskopik sporlar sayəsində demək olar ki, qarşısıalınmaz bir təhlükə yaradır.
Bu sporlar nəzərə çarpmadan tənəffüs olunur və xüsusilə zəif immun sistemi olan şəxslərdə ciddi ağciyər infeksiyalarına səbəb ola bilər.
Göbələklərin yaratdığı bir xəstəlik olan aspergilloz orqan çatışmazlığı və ölümlə nəticələnə bilər. Xərçəng, astma və ya HİV kimi immunitet sistemini zəiflədən xəstəlikləri olan şəxslər ən yüksək risk altındadırlar.
Günel Məlikzadə




